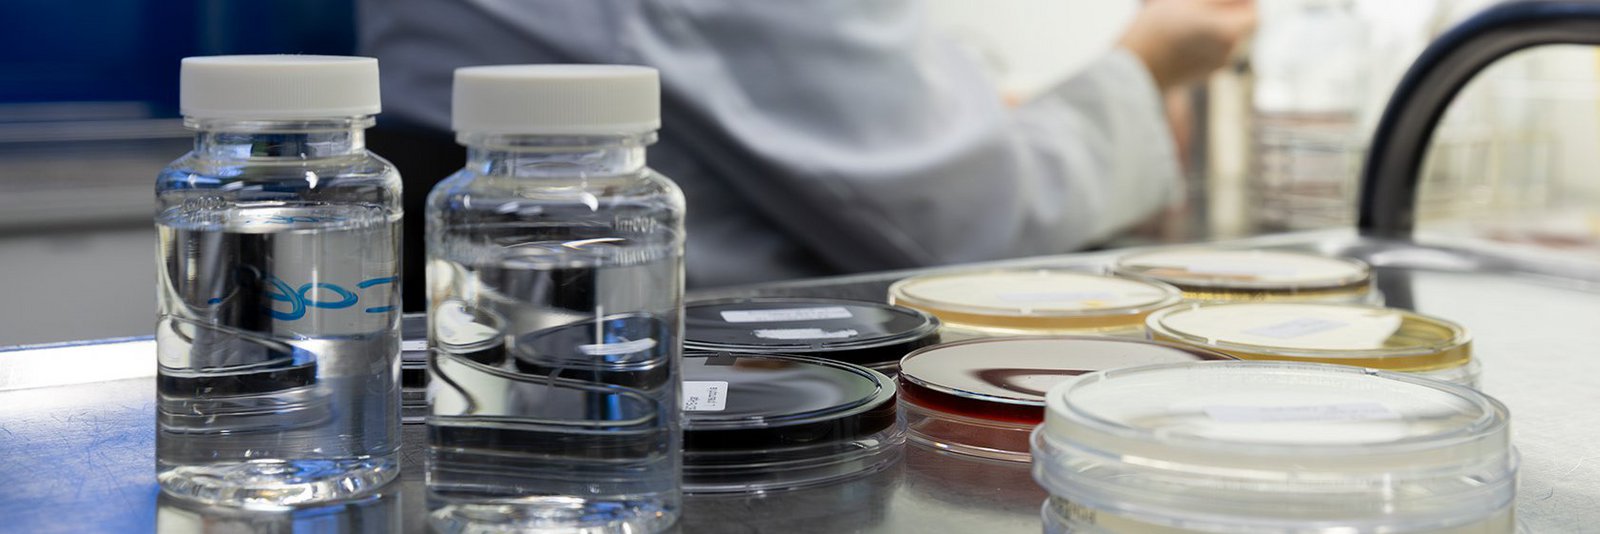
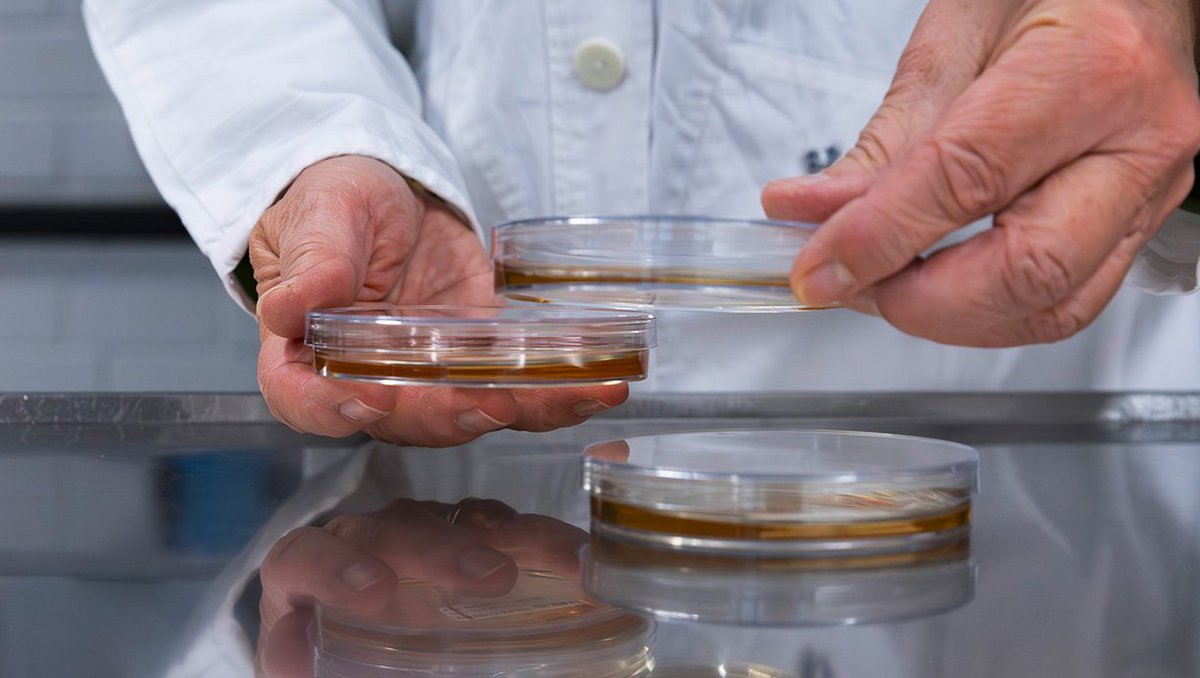

Wir übernehmen Verantwortung – Vertrauen als Basis der Zusammenarbeit
Die Mitarbeiter und Mitarbeiterinnen der WWU sind Experten in allen Themengebieten rund um das Thema Wasser.
Mit unserem langjährigen Wissen planen wir die für unsere Kunden passend zugeschnittenen Lösungswege und stehen ihnen auch in Krisensituationen zur Seite.
Um unsere Kunden bestmöglich zu kennen und beraten zu können, nehmen wir an Betriebsbesprechungen teil und unterstützen Behördentermine.
In Sondersituation können Sie sich auf unsere Bereitschaftsdienste verlassen; auch die mikrobiologische Analytik ist 365 d/a besetzt.
Klare Lösungen

Leistungspakete der WWU
Unser WWU-Team sorgt dafür, dass die gesamte Prozesskette von der Trinkwassergewinnung bis zur Verteilung nach gesetzlichen Vorgaben und Regelwerken kontrolliert und bewertet wird.
Mit klarer Kommunikation und jederzeit für Sie da. Bestmöglich begleitet und beraten.